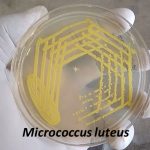
Micrococcus luteus
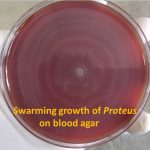
Swarming growth of Proteus

Collection Group: Clinical Bacteriology
Oxidase Test for Bacteria: Introduction, Principle, Procedure, Result Interpretation and Keynotes
 Introduction of Oxidase Test (Kovac's Method) Oxidase test negative and...
Introduction of Oxidase Test (Kovac's Method) Oxidase test negative and...
Micrococcus: Introduction, Classification, Morphology, Pathogenecity, Lab Diagnosis
Micrococcus Micrococcus luteus growth on nutrient agar is bright mustard-yellow...
Micrococcus Micrococcus luteus growth on nutrient agar is bright mustard-yellow...
Swarming Growth of Proteus on Blood Agar: Description of Swarming and Proteus Details
Swarming Growth of Proteus on Blood Agar Swarming growth of...
Swarming Growth of Proteus on Blood Agar Swarming growth of...
